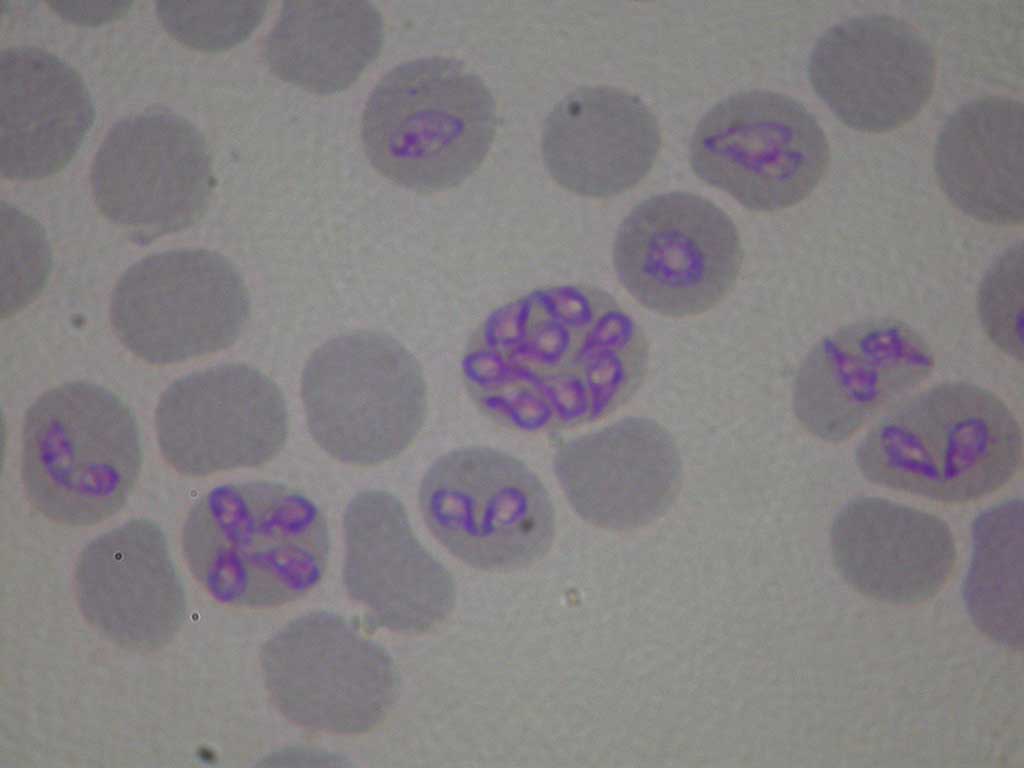

Überblick Babesiose

Dermacentor reticulatus ♂
Babesia canis

Dermacentor reticulatus ♀
Allgemeines:
Bei der Hundebabesiose handelt es sich um eine parasitäre Infektionserkrankung, die durch Babesia Arten hervorgerufen wird und von Zecken übertragen wird. Babesien befallen die roten Blutkörperchen und zerstören diese.
Erreger:
In Europa beim Hund: Babesia canis (Ungarn- und Frankreich-Stamm), Babesia vogeli, Babesia vulpes. Keine Zoonose.
Überträger/Übertragung/Wirte:
Überträger:
Zecken:
Babesia canis: Auwaldzecke (Dermacentor reticulatus)
Babesia vogeli: Braune Hundezecke (Rhipicephalus sanguineus).
Babesia vulpes: Vermutlich Igelzecke (Ixodes hexagonus).
Übertragung:
48 bis 72 Stunden nach Zeckenstich, aktivierte Dermacentor reticulatus bereits nach 12 Stunden.
Inkubationszeit: 5 Tage bis 3 Wochen.
Präpatenz: 7 Tage.
Patenz: Ohne Therapie lebenslang.
Wirte: Hund.
Verbreitung:
Babesia canis (Ungarn-Stamm): Deutschland (Berlin, Brandenburg, Sachsen, Sachsen-Anhalt, Thüringen), Polen, Ungarn, Rumänien, Ukraine.
Babesia canis (Frankreich-Stamm): Deutschland (Rheinland-Pfalz, Saarland, Baden-Württemberg, Hessen), Frankreich, Spanien (Navarra, Katalonien, Aragonien), Italien (Piemont, Ligurien), Nord-Schweiz.
Babesia vogeli: Südeuropa (Zentral- und Südspanien, Portugal, Zentral- und Süditalien, Griechenland).
Babesia vulpes: Nordspanien, Südfrankreich, Norditalien.
Babesia gibsoni: Asien, USA.
Mischgebiete mit Überschneidung der verschiedenen Arten sind möglich.
Diagnostik:
Babesia canis, Babesia vogeli:
Akut: Direkter Erregernachweis aus Kapillarblut (z.B. Giemsa-gefärbter Ausstrich) und/oder PCR aus EDTA-Blut.
Chronisch: Antikörpertiter als IFAT/ELISA.
Babesia vulpes: Kleine Babesien, daher Mikroskopie schwierig. Molekularer Nachweis per PCR sicher.
DD: Toxische/medikamentöse/(auto-)immunhämolytische Anämie (IMHA), Systemischer Lupus Erythematodes (SLE), Mycoplasmose, Anaplasmose, Ehrlichiose.
Die Babesiose tritt häufig in Begleitung von Co-Infektionen auf. Bei der Diagnostik muss daher unbedingt ein komplettes Reiseprofil (Link zu Untersuchungsauftrag) entsprechend des Herkunftslandes erstellt werden.
Symptome:
Akut: Hämolyse, Anämie, Bilirubinurie, Hämoglobinurie („Cola-farbener“ Urin), Retikulozytose, seltener Thrombozytopenie, Fieber bis 42°C, Appetitlosigkeit, Mattigkeit, Blutungsneigung, blasse Schleimhäute, Ikterus, Katarrh und Stomatitis, Gastritis, Myositis, seltener Ödembildung, Aszites, Splenomegalie, Hepatomegalie, Bewegungsstörungen, epileptiforme Anfälle.
Chronisch: Anämie, Abmagerung, Apathie, Leistungsschwäche, Lethargie, Niereninsuffizienz.
Subklinisch: Leichtes Fieber, Anämie, Apathie (intermittierend).
Labor:
Blut: Gesamteiweiß (TP) ↑, Albumin ↓, γ-Globuline ↑, Erythrozyten (RBC) ↓, Hämatokrit (HCT) ↓, Hämoglobin (HGB) ↓, Thrombozyten (PLT) ↓, Leukozyten (WBC) ↓, Bilirubin ↑, Leberenzyme (ALT, AST) ↑, Kreatinin (Crea) ↑, Harnstoff (Urea) ↑.
Urin: Bilirubin ↑, Hämoglobin ↑.
Behandlung:
Imidocarb-Dipropionat (als subkutane Injektion):
Babesia vogeli: Der Erreger gilt mit Stand April 2021 als wenig pathogen und muss nicht unbedingt behandelt werden. Da zudem der Vektor Braune Hundezecke in Deutschland nicht heimisch ist, stellen infizierte Hunde keine Gefahr für unsere einheimische Population dar. Therapie bei symptomatischen Hunden: Zwei Injektionen therapeutischer Dosis (siehe Packungsbeilage), Erreger gilt als eliminiert.
Babesia canis (Frankreich-Stamm): Zwei Injektionen prophylaktischer Dosis (siehe Packungsbeilage), Erreger gilt nur bei der prophylaktischen Dosis als eliminiert. PCR-Kontrolle aus EDTA-Blut 1 Woche nach zweiter Injektion sinnvoll.
Babesia canis (Ungarn-Stamm): Zwei Injektionen prophylaktischer Dosis, Erregerelimination fraglich. PCR-Kontrolle aus EDTA-Blut eine Woche nach zweiter Injektion zwingend nötig! Wenn PCR weiterhin positiv, muss Erregertypisierung erfolgen.
Babesia vulpes: Präparate aus der Malaria-Therapie, bitte aktuelle Therapie erfragen!
Notfallmaßnahmen: Bluttransfusion (HCT < 15-20 %), Intensivtherapie (Dialyse, Infusion).
Cave: Imidocarb bei vorbestehenden Leber- und Nierenerkrankungen vorsichtig einsetzen. Bei diesem Präparat gibt der Hersteller die Dosierung pro 10 kg Hund an! Die subkutane Injektion ist der intramuskulären Injektion zu bevorzugen, da die i.m.-Injektion des Wirkstoffes extrem schmerzhaft ist und zu Abszessen und Nekrosen führen kann. Zudem ist bei i.m.-Injektion aufgrund der schnelleren Resorptionsrate die Gefahr der Nebenwirkungen erhöht (Speicheln, gastrointestinale Störungen, Leber- und Nierenversagen). Präparat nicht intravenös verabreichen!
Vorbeugung:
Impfprophylaxe: Aktuell ein Impfstoff auf dem Markt, in Deutschland nicht zugelassen.
Chemoprophylaxe: Imidocarb-Dipropionat: Eine Injektion prophylaktischer Dosis. Verabreichung bei Reiseantritt, Schutzwirkung max. 3-4 Wochen. Beim Ungarn-Stamm von Babesia canis ungenügende Schutzwirkung.
Prävention: Zum Beispiel permethrinhaltige und flumethrinhaltige Spot ons und/oder Halsbänder. Lassen Sie sich in diesem Fall rechtzeitig vor Reiseantritt von uns oder ihrem Tierarzt beraten.
Verhaltensprophylaxe: Zeckenbiotope meiden. Hunde sollten während der Risikozeiten nicht in Risikogebiete reisen.
Wichtig: Reisebegleitende Hunde erkranken in der Regel wesentlich schwerer als im Land lebende Hunde, weil sie nicht an die Erreger adaptiert sind. Die Babesiose kann bei diesen Tieren perakut verlaufen und innerhalb von wenigen Tagen zum Tode führen.
Der Ungarnstamm der Babesiose zeigt sich häufig in extrem hohen Titern. Diese hohe Antikörperproduktion fordert das Immunsystem, was sich in stumpfem Fell, Hautveränderungen und allgemeiner Mattigkeit zeigen kann. Es wird daher empfohlen, den Ungarnstamm auch bei fehlenden Blutbildveränderungen zu therapieren, insbesondere, da der Hund ohne Therapie lebenslang Überträger bleibt.
